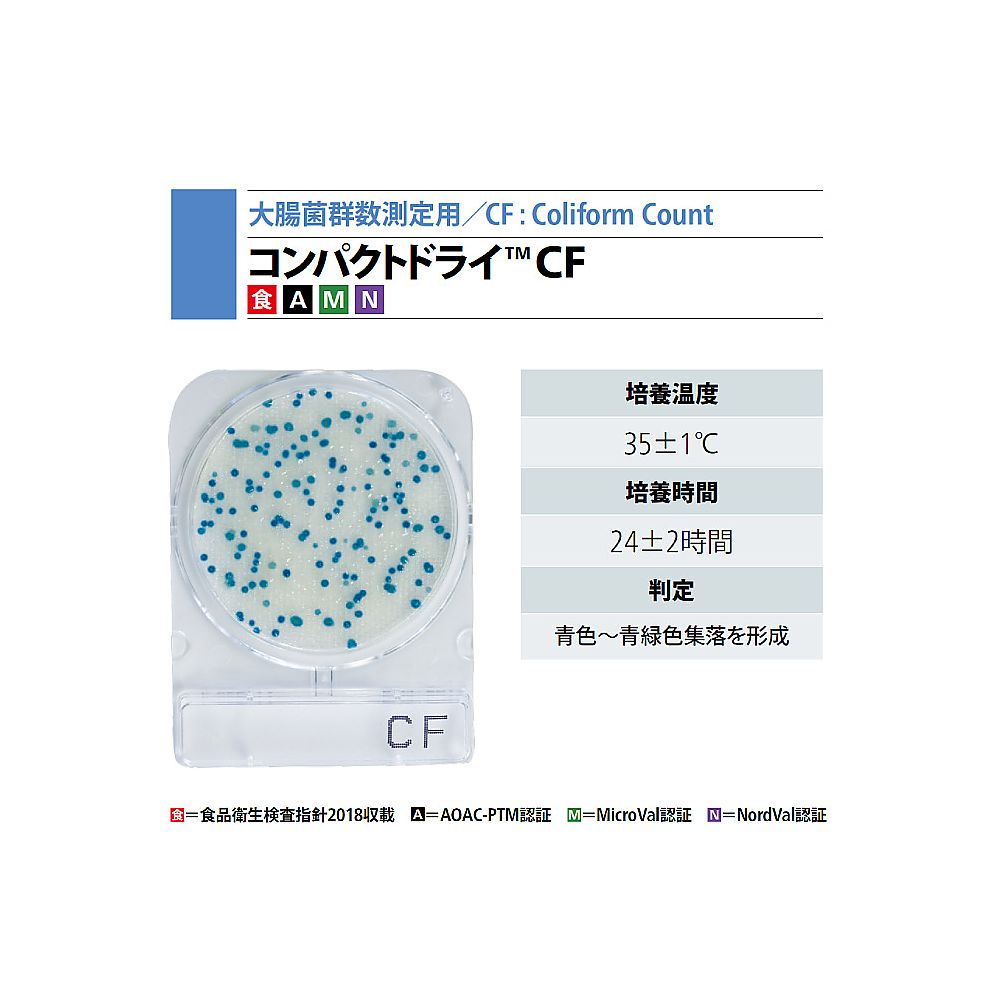
コンパクトドライ （大腸菌群数測定用/4枚×10袋） 06744CF

|
商品番号
|
商品名・規格・入数 |
通常価格 |
販売価格
|
注文数 |
|
2-9024-04
製品番号:6745
|
コンパクトドライ (大腸菌群数測定用/4枚×60袋) 06745CF
11箱(4枚×60袋入り)
(11箱(4枚×60袋入り)あたり23,280円(税込10% 25,608円))
|
- メーカー希望小売価格
-
24,000円
(税込 26,400円)
|
-
-
23,280 円
(税込 25,608 円)
|
ご注文にはログインが必要です
|
|

2-8998-07
製品番号:6748
|
コンパクトドライ (腸炎ビブリオ測定用/4枚×10袋) 06748VP
11箱(4枚×10袋入り)
(11箱(4枚×10袋入り)あたり5,240円(税込10% 5,764円))
|
- メーカー希望小売価格
-
5,400円
(税込 5,940円)
|
-
-
5,240 円
(税込 5,764 円)
|
ご注文にはログインが必要です
|
|

2-9024-07
製品番号:6749
|
コンパクトドライ (腸炎ビブリオ測定用/4枚×60袋) 06749VP
11箱(4枚×60袋入り)
(11箱(4枚×60袋入り)あたり23,280円(税込10% 25,608円))
|
- メーカー希望小売価格
-
24,000円
(税込 26,400円)
|
-
-
23,280 円
(税込 25,608 円)
|
ご注文にはログインが必要です
|
|

2-8998-06
製品番号:6746
|
コンパクトドライ (酵母|カビ測定用/4枚×10袋) 06746YM
11箱(4枚×10袋入り)
(11箱(4枚×10袋入り)あたり9,700円(税込10% 10,670円))
|
- メーカー希望小売価格
-
10,000円
(税込 11,000円)
|
-
-
9,700 円
(税込 10,670 円)
|
ご注文にはログインが必要です
|
|

2-9024-06
製品番号:6747
|
コンパクトドライ (酵母|カビ測定用/4枚×60袋) 06747YM
11箱(4枚×60袋入り)
(11箱(4枚×60袋入り)あたり39,580円(税込10% 43,538円))
|
- メーカー希望小売価格
-
40,800円
(税込 44,880円)
|
-
-
39,580 円
(税込 43,538 円)
|
ご注文にはログインが必要です
|
|

2-8998-02
製品番号:6729
|
コンパクトドライ (黄色ブドウ球菌測定用/4枚×10袋) 06729X-SA
11箱(4枚×10袋入り)
(11箱(4枚×10袋入り)あたり8,150円(税込10% 8,965円))
|
- メーカー希望小売価格
-
8,400円
(税込 9,240円)
|
-
-
8,150 円
(税込 8,965 円)
|
ご注文にはログインが必要です
|
|

2-9024-02
製品番号:6730
|
コンパクトドライ (黄色ブドウ球菌測定用/4枚×60袋) 06730X-SA
11箱(4枚×60袋入り)
(11箱(4枚×60袋入り)あたり37,250円(税込10% 40,975円))
|
- メーカー希望小売価格
-
38,400円
(税込 42,240円)
|
-
-
37,250 円
(税込 40,975 円)
|
ご注文にはログインが必要です
|
|

2-8998-05
製品番号:6740
|
コンパクトドライ(TM) TC(生菌数測定用)4枚×10袋
11箱(4枚×10袋入り)
(11箱(4枚×10袋入り)あたり5,240円(税込10% 5,764円))
|
- メーカー希望小売価格
-
5,400円
(税込 5,940円)
|
-
-
5,240 円
(税込 5,764 円)
|
ご注文にはログインが必要です
|
|

2-9024-12
製品番号:4299
|
-
 取寄せ
取寄せ
コンパクトドライ(TM) 04299 カテキン中和剤入り一般生菌数測定用 4枚/袋x60袋入
11箱(4枚×60袋入り)
(11箱(4枚×60袋入り)あたり26,400円(税込10% 29,040円))
|
- メーカー希望小売価格
-
26,400円
(税込 29,040円)
|
-
-
26,400 円
(税込 29,040 円)
|
ご注文にはログインが必要です
|
|

2-8998-01
製品番号:6742
|
コンパクトドライ(TM) EC(大腸菌・大腸菌群数測定用) 4枚×10袋 06742
11箱(4枚×10袋入り)
(11箱(4枚×10袋入り)あたり9,700円(税込10% 10,670円))
|
- メーカー希望小売価格
-
10,000円
(税込 11,000円)
|
-
-
9,700 円
(税込 10,670 円)
|
ご注文にはログインが必要です
|
|

2-8998-09
製品番号:6535
|
コンパクトドライ(TM) ETB(腸内細菌科細菌群数測定用) 4枚×10袋 06535
11箱(4枚×10袋入り)
(11箱(4枚×10袋入り)あたり5,240円(税込10% 5,764円))
|
- メーカー希望小売価格
-
5,400円
(税込 5,940円)
|
-
-
5,240 円
(税込 5,764 円)
|
ご注文にはログインが必要です
|
|

2-8998-03
製品番号:6732
|
コンパクトドライ(TM) SL(サルモネラ属菌測定用) 4枚×10袋 06732
11箱(4枚×10袋入り)
(11箱(4枚×10袋入り)あたり5,240円(税込10% 5,764円))
|
- メーカー希望小売価格
-
5,400円
(税込 5,940円)
|
-
-
5,240 円
(税込 5,764 円)
|
ご注文にはログインが必要です
|
|

63-5753-45
製品番号:6777
|
コンパクトドライ(TM) YMR(カビ・酵母迅速測定用) 40枚 06777
11箱(4枚×10袋入り)
(11箱(4枚×10袋入り)あたり11,640円(税込10% 12,804円))
|
- メーカー希望小売価格
-
12,000円
(税込 13,200円)
|
-
-
11,640 円
(税込 12,804 円)
|
ご注文にはログインが必要です
|
|

2-5966-01
製品番号:HKB
|
コーンラージ棒 1袋(10本入) HKB
11袋(10本入り)
(11袋(10本入り)あたり2,950円(税込10% 3,245円))
|
- メーカー希望小売価格
-
3,600円
(税込 3,960円)
|
-
-
2,950 円
(税込 3,245 円)
|
ご注文にはログインが必要です
|
|

2-7979-01
製品番号:HKB3
|
コーンラージ棒 1袋(10本入) HKB3
11袋(10本入り)
(11袋(10本入り)あたり2,620円(税込10% 2,882円))
|
- メーカー希望小売価格
-
3,200円
(税込 3,520円)
|
-
-
2,620 円
(税込 2,882 円)
|
ご注文にはログインが必要です
|
|

2-6391-06
製品番号:ソフト(フィルター付き)
|
サニスペックテストバッグ 1ケース(250枚×2箱入) ソフト(フィルター付き)
11ケース(250枚×2箱入り)
(11ケース(250枚×2箱入り)あたり11,750円(税込10% 12,925円))
|
- メーカー希望小売価格
-
13,500円
(税込 14,850円)
|
-
-
11,750 円
(税込 12,925 円)
|
ご注文にはログインが必要です
|
|

2-6391-54
製品番号:エコ(フィルター付き)
|
サニスペックテストバッグ ケース販売 1ケース(500枚×10箱入) エコ(フィルター付き)
11ケース(500枚×10箱入り)
(11ケース(500枚×10箱入り)あたり135,240円(税込10% 148,764円))
|
- メーカー希望小売価格
-
147,000円
(税込 161,700円)
|
-
-
135,240 円
(税込 148,764 円)
|
ご注文にはログインが必要です
|
|

2-6391-56
製品番号:ソフト(フィルター付き)
|
サニスペックテストバッグ ケース販売 1ケース(500枚×10箱入) ソフト(フィルター付き)
11ケース(500枚×10箱入り)
(11ケース(500枚×10箱入り)あたり115,710円(税込10% 127,281円))
|
- メーカー希望小売価格
-
133,000円
(税込 146,300円)
|
-
-
115,710 円
(税込 127,281 円)
|
ご注文にはログインが必要です
|
|

2-6391-51
製品番号:フィルター付き
|
サニスペックテストバッグ ケース販売 1ケース(500枚×10箱入) フィルター付き
11ケース(500枚×10箱入り)
(11ケース(500枚×10箱入り)あたり151,800円(税込10% 166,980円))
|
- メーカー希望小売価格
-
165,000円
(税込 181,500円)
|
-
-
151,800 円
(税込 166,980 円)
|
ご注文にはログインが必要です
|
|

2-6391-52
製品番号:フィルター無し
|
サニスペックテストバッグ ケース販売 1ケース(500枚×10箱入) フィルター無し
11ケース(500枚×10箱入り)
(11ケース(500枚×10箱入り)あたり105,800円(税込10% 116,380円))
|
- メーカー希望小売価格
-
115,000円
(税込 126,500円)
|
-
-
105,800 円
(税込 116,380 円)
|
ご注文にはログインが必要です
|